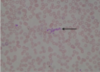

BSL-1
Organisms which do not typically cause disease in healthy humans. (E. coli)
BSL-4
Organisms that pose a lethal health risk to humans. (Ebola and Smallpox viruses)
Oculars
Magnify the image 10x
Objectives lenses
Magnify the image (4x-low
Revolving Nosepiece
Rotates objectives into viewing position
Stage
Supports the specimen for viewing
Specimen Holder
Holds the slide firmly in place
Light Switch
Turns light source on/off
Light Source
Provides light to illuminate the specimen
Light Intensity Knob
Adjusts intensity of the light source
Iris Diaphragm Lever
Controls the amount of light entering the aperture
Condenser
Focuses light on the specimen
Coarse Focus Knob
Rapidly brings the specimen into focus; use first at low power
Fine Focus Knob
Slowly brings the specimen into focus; use at high power
Mechanical Stage Controls
Move the slide forward & back
Define working distance
The distance between a slide specimen and the objective lens in use
Define field of view
Viewing area when looking through the ocular of a microscope
Define parfocal
The ability of a microscope to stay in rough focus with changes in magnification
Flatworms are classified in Phylum _________
Platyhelminthes
roundworms are classified in Phylum ___________
Nematoda
Which kingdom do worms belong to?
animalia
Walking around barefoot in the summer puts one at increased risk of infestation from what parasitic worm?
hookworm
Liquid growth media vs solid growth media
Liquid : nutrient broth
Solid : nutrient agar
Ubiquity
The ability to survive in almost any environment